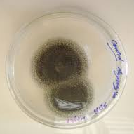
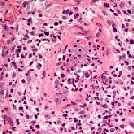

Neusaandoeningen
Hier worden 40 verschillende neusaandoeningen toegelicht.

Allergie
Inhalatieallergie heeft op deze website een aparte plaats gekregen, gezien het grote maatschappelijke belang.

Choanaal atresie
De achteruitgang van de neus heet choane. Bij de geboorte kan deze aan één of beide kanten zijn afgesloten.

Cocaïne neus
Cocaïne-gebruik via de neus kan drie ernstige problemen geven: neusbloedingen, necrose van de huid, neustussenschotperforatie en een beeld gelijkend op een empty nose.

Corpus alienum
Een vreemd lichaam wordt corpus alienum genoemd en hoort niet in de neus thuis. Een corpus alienum moet altijd worden verwijderd.

Empty nose syndrome
![]()
Van binnen worden de linker en rechter neusholte verkleind door enkele zwellichamen, de zogenoemde neusschelpen. Deze zorgen – als het goed is – voor goede doorgankelijkheid van de in- en uitademingslucht. Bij te weinig neusschelp kan het empty nose (lege neus) syndroom (ENS) ontstaan.

GPA
GPA staat voor Granulomatose met Polyangiitis en werd voorheen de ziekte van Wegener genoemd.
Het is een Primaire (onbekende oorzaak) Systemische (het gehele lichaam kan zijn aangedaan) Vasculitis (ontstekingen van de binnenwanden van de kleine bloedvaten).

Hoofdpijn
Hoofdpijnklachten worden zelden veroorzaakt door een neusprobleem, maar iets vaker door neusbijholtenproblemen (sinusitis).

Hump
KNO-artsen noemen een bochel van de neusrug een hump. Deze wordt gevormd door een combinatie van bot en/of kraakbeen.

Korstvorming in de neus
Als er korsten in de neus zitten, is er altijd iets met de neus aan de hand.
Bij korstvorming in de neus is er altijd schade van het slijmvlies.

Loopneus
Een loopneus met dun helder snot is meestal een gevolg van verkoudheid of inhalatieallergie, het kan ook worden
veroorzaakt door ontregeling van het neusslijmvlies.

Neusbijholtenontsteking
Aan de twee neusgangen grenzen neusbijholten. Bij slechte doorgankelijkheid van deze neusgangen naar de neusbijholten kan het bekledende slijmvlies van de neusbijholten ontsteken.

Neusbloeding
Een neusbloeding (epistaxis) is vervelend. Een bloeding lijkt (gelukkig) meestal erger dan het is.

Neuscontusie
Een kneuzing van de neus heet een neuscontusie. Er is dan weefselschade met zwelling, maar geen botbreuk, zoals bij een neusfractuur.

Neusdruppelverslaving
Neusdruppel- of neussprayverslaving komt veel voor. Het heeft niets te maken met alcohol- of drugsverslaving.

Neusfractuur
Als het neusbot is gebroken dan noemen wij dat een neusbreuk of neusfractuur. Er is dan altijd zwelling en blauwe verkleuring van de huid naast de neus (en rond één of twee ogen).

Neusfurunkel
Een neusfurunkel (of steenpuist) ontstaat door een ontsteking van de huid (naast, op of bij de ingang) van de neus.
Neuskanker - inwendig
Kanker kan voorkomen in de neusgang en neusbijholten (sinussen).
Neuskanker - uitwendig
Uitwendige neuskanker is meestal een vorm van huidkanker. Er zijn diverse soorten van huidkanker, elk met hun eigen klachten, symptomen, risico’s en behandelingsopties.

Neusklepprobleem
Het kraakbeen in de neusvleugels wordt gedurende het leven slapper, waardoor de neusvleugels bij (krachtige) inademing tegen het neustussenschot worden aangezogen. Dit geeft het gevoel van benauwdheid.

Neuspoliepen
Neuspoliepen zijn goedaardige plaatselijke zwellingen van het neusslijmvlies.

Neusschelpzwelling
De neusschelpen vergroten het binnenoppervlak van de twee neusgangen als verwarmingsradiatoren. Zij zijn
bekleed met slijmvlies. De neusschelpen kunnen te groot zijn en/of het slijmvlies te veel gezwollen waardoor de neusgangen te nauw worden. Klachten van neusverstopping zijn daarvan het gevolg.
Neusschimmel
Neusschimmel, ook wel schimmel in de neus genoemd, verwijst naar de aanwezigheid van schimmels in de neusholte.

Neusspraak
Er is sprake van een neusspraak of nasaliteitsstoornis wanneer de klank (resonantie) van de spraak afwijkend is: de spraak klinkt te veel of juist te weinig door de neus.

Neustussenschotperforatie
Als het slijmvlies van het neustussenschot aan beide zijden beschadigt (bijvoorbeeld door operatie, trauma, peuteren, cocaïne), dan valt de bloedvoorziening van het kraakbeen weg en sterft het kraakbeen af, waardoor er een gat in het tussenschot
ontstaat.

Neusverstopping
Er zijn veel oorzaken van neusverstopping.

Niesen / niezen
Niesen of niezen is een reflex op een prikkel in de neus. Het is geen neusaandoening, maar kan een klacht zijn passend bij een neusaandoening.

Ontregeld neusslijmvlies
![]()
Het neusslijmvlies volgt normaal een zogeheten neuscylus van
zwellen aan de ene kant en slinken aan de andere kant (circadiaan ritme). Bij verstoring van het ritme, dat normaal van kant wisselt binnen één of meer uren, kan neusverstopping optreden, doordat het neusslijmvlies gaat zwellen en/of meer neusslijm wordt gemaakt.
Verstoringen kunnen verschillende oorzaken hebben.

Postnasale drip
Wanneer er (vies) slijm achter uit de neus achterlangs in de keel loopt, wordt postnasale drip genoemd.

Primaire ciliaire dyskinesie
Primaire ciliaire dyskinesie (PCD) is een erfelijke aandoening van de trilharen. Bij PCD bewegen de trilharen o.a. in de neus niet goed.

Rendu Osler Weber
De ziekte van Rendu-Osler-Weber (ROW) is een erfelijke aandoening van de bloedvaten. De oorzaak is een verandering in het DNA (erfelijk materiaal).

Reukstoornis
De meest voorkomende oorzaken voor het ontstaan van een reukstoornis zijn: een trauma aan het hoofd, sinonasale afwijkingen (zoals chronische ontstekingen) of ontsteking van de bovenste luchtwegen.

Rhinophyma
Rhinophyma is een huidaandoening met uitgebreide vervorming van de neus. Het ontstaat door de groei van bindweefsel en talgklieren in de huid.

Scheefstand neustussenschot
Maar 10% van alle neustussenschotten staat kaarsrecht in het midden van de neus. Er zijn veel verschillende afwijkingen van het neustussenschot die geen klachten geven.

Scheefstand uitwendige neus
De uitwendige neus kan scheef uitgroeien, meestal na een trauma van het aangezicht. Op jonge leeftijd is een trauma vervelender, omdat het de uitgroei meer beïnvloedt.

Septumhaematoom
Een septumhaematoom ontstaat na een trauma van de neus of na neuschirurgie.
Er ontstaat een bloeding in het neustussenschot (septum) tussen het bloedvoorzienende kraakbeenvlies aan beide kanten. Dit vlies is dan beschadigd aan de binnenzijde door uitstekend kraakbeen.

Snot
Snot kan er op veel manieren uitzien. Snot zegt soms iets over de oorzaak van de neusaandoening. Er kan een onderscheid gemaakt worden tussen helder, wit, geel, groen, rood, bruin en zwart snot.
Vasculitis
Vasculitis is de verzamelnaam voor een aantal ziektebeelden waarbij de binnenwand van de bloedvaten ontstoken raakt.

Vestibulitis
Een ontsteking van de huid bij de ingang (vestibulum) van de neus heet een vestibulitis nasi. Deze ontsteking ontstaat door beschadiging van de huid (een haartje uittrekken bijvoorbeeld).

Voorste zeefbeencelontsteking
Dé oorzaak van een ontsteking van de voorste zeefbeencellen is een banale verkoudheid en komt bij kinderen veel meer voor dan bij volwassenen.

Zadelneus
Een zadelneus ontstaat als de kraakbenige steun van het neustussenschot wegvalt, bijvoorbeeld als complicatie na neustussenschotchirurgie, cocaïnegebruik of trauma.











